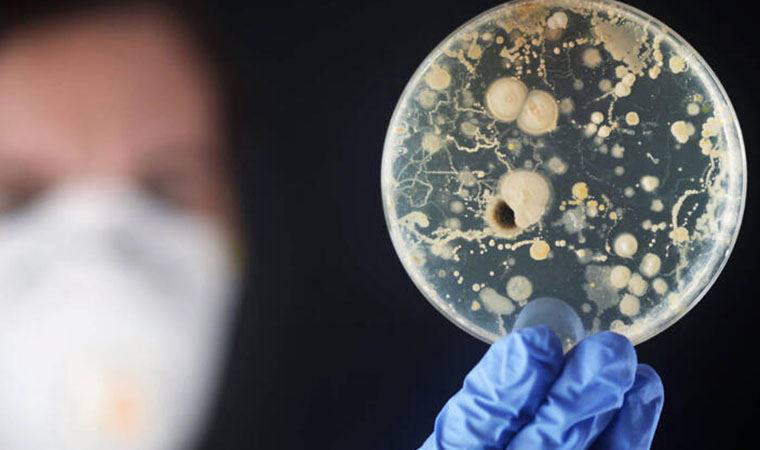

Koronavirüs salgınıyla sarsılan ABD'nin Florida eyaletinde bir kişi 'naegleria fowleri' adlı tek hücreli organizmanın yol açtığı hastalığa yakalandı. Burundan girerek beyine yerleşen amipin bir haftada ölüme yol açtığının açıklanmasının ardından Türkiye’de de bu tür vakalara rastlandığı belirtildi. Enfeksiyon Hastalıkları ve Mikrobiyoloji Uzmanı Prof. Dr. Gülgün Dilek Arman, ‘naegleria fowleri’ adlı organizmanın yanında 'akantamoba' adı verilen bir organizmanın olduğunu, bunun da gözden girerek beyinde lezyon yaptığını anlattı.

“KAYNAK SULARINDA GÖRÜLEBİLİYOR”
Amip adı verilen bakterinin özellikle tatlı sularda yaşadığını ifade eden Prof. Arman, "'Naegleria fowleri' şu günlerde gündemde ancak akantamoba da her yerde seyrek ancak nispeten sık görüldüğü Amerika'da fazla görülen formu. Naegleria Fowleri özellikle menenjite yol açıyor, akantamoba da vücuda daha çok gözden girerek bazen beyinde lezyon yapabiliyor. Menenjite ve beynin iç kısmının iltihabına yol açabiliyor. Tedavisi oldukça güç. Çoğu olguda yaşam kaybıyla sonlanan zor klinik tablolar gözleniyor. Virüslerin kaynağı tatlı sular. Daha çok ‘vahşi doğa’ diyebileceğimiz alanlarda Amerika'da seyrek de olsa görülen bir tablo. Yapılmış araştırmalara baktığımızda bu virüslerin Türkiye ve dünyanın pek çok ülkesinde özellikle kaynak sularında çok yaygın görülebildiğini biliyoruz. Ancak vücuda girmesi kolay değil. Mikroorganizmanın burundan girerek arkasındaki silüsü geçip beyne ulaşması, sık görülmesine engel olan en önemli faktör ama sularda oldukça yaygın bulunabildiğini de göz ardı etmemeliyiz” diye konuştu.
“GÖZDEKİ EN UFAK KIZARIKLIKTA HEKİME BAŞVURUN”
Özellikle lens kullanan kişilerin dikkatli olması gerektiği uyarısında bulunan Prof. Arman, şunları söyledi:
"Yüzü yıkadığımız suların temiz olduğundan emin olmak önemli. Türkiye’de vaka olarak düşündüğümüzde 2009'da Ankara'da tanımlanmış bir vaka var. Sonra Eskişehir'de bir vaka görülmüş. 2018'de Gürcistan'dan gelen bir kişi İstanbul'da tanı almış. Türkiye'de oldukça seyrek olduğunu söyleyebiliriz. Dikkat etmemiz gereken nokta, temiz olmayan tatlı sularda yüzmemek. Akarsu, göl gibi alanlarda yüzmekten kaçınmak gerekiyor. Klorlama yeterli olmayabilir. Temiz bir kaynaktan gelmeyen bir suyla doldurulmuş havuzda da klorlama da yeterli olmayabilir. Özellikle göz temizliğinde kullandığımız ve yüzdüğümüz suyun temizliğine dikkat edelim. En ufacık bir belirtide, gözde çok önemsemediğimiz minik de olsa bir kızarıklık olduğu durumlarda mutlaka bir göz hekimine giderek muayene olmalıyız. Menenjit bulguları ağır olgulardır. Yüksek ateş, baş ağrısı, kusma durumunda da kişi vakit kaybetmeden hekime gitmelidir."

“BEYNE ULAŞTIĞINDA AĞRI KESİCİLER YANIT VERMİYOR”
Amipin sıcak ortamları seven bir bakteri olduğunu anlatan Beyin ve Sinir Cerrahisi Uzmanı Opr. Dr. Halil Olgün Peker ise “Burundan girerek burun mukozasından burun siniri yoluyla beyne kadar ulaşıyor. Beyinde şiddetli bir menenjit tablosuna yol açıyor. Bu tablo çok ağır ve hızlı geliştiğinden hastalarda kısa süre içerisinde ölümle sonuçlanıyor. Bu nedenle tedavisi halen net olarak bulunamamış bir hastalık. Hastalığın 5-10 günlük bir periyodu var. Virüs önce burundan giriyor ve burada bir burun enfeksiyonu, sinüzit bulguları oluşturuyor. Sonra burun tıkanıklığı ve ateş belirtileri görülüyor. Beyne ulaştığında ise ağrı kesicilere cevap vermeyen bir baş ağrısı yaşanıyor. Bunun dışında ense sertliği ve şuur değişiklikleri gibi şikâyetlere bile yol açıp hastaları komaya sokabiliyor. Ani beyin ödemi sonrasında da hastalar hayatını kaybediyor” ifadelerini kullandı.
“İNSANDAN İNSANA BULAŞMIYOR”
Hastalığın insandan insana bulaşıcı bir özelliğinin olmadığına dikkat çeken Peker, “Bulaşıcı bir özelliği yok. İnsandan insana bulaşmaz. Sadece sıcağı sever. En çok sevdiği sıcaklık ise 46 derece civarıdır. İnsanlara sıcak sulardan bulaşır. Hasta birinden başka bir hastaya bulaşması söz konusu değil. Amerika'da bugüne kadar tespit edilen 145 vaka var. Bunlardan sadece 3'ü hayatta kalabilmiş, diğerlerinin hepsi hayatını kaybetmiş. Diğer hastalıklar arasında çok sık gözüken bir hastalık değil. İnsanların korkmasını gerektirecek bir durum olduğunu düşünmüyorum” dedi.